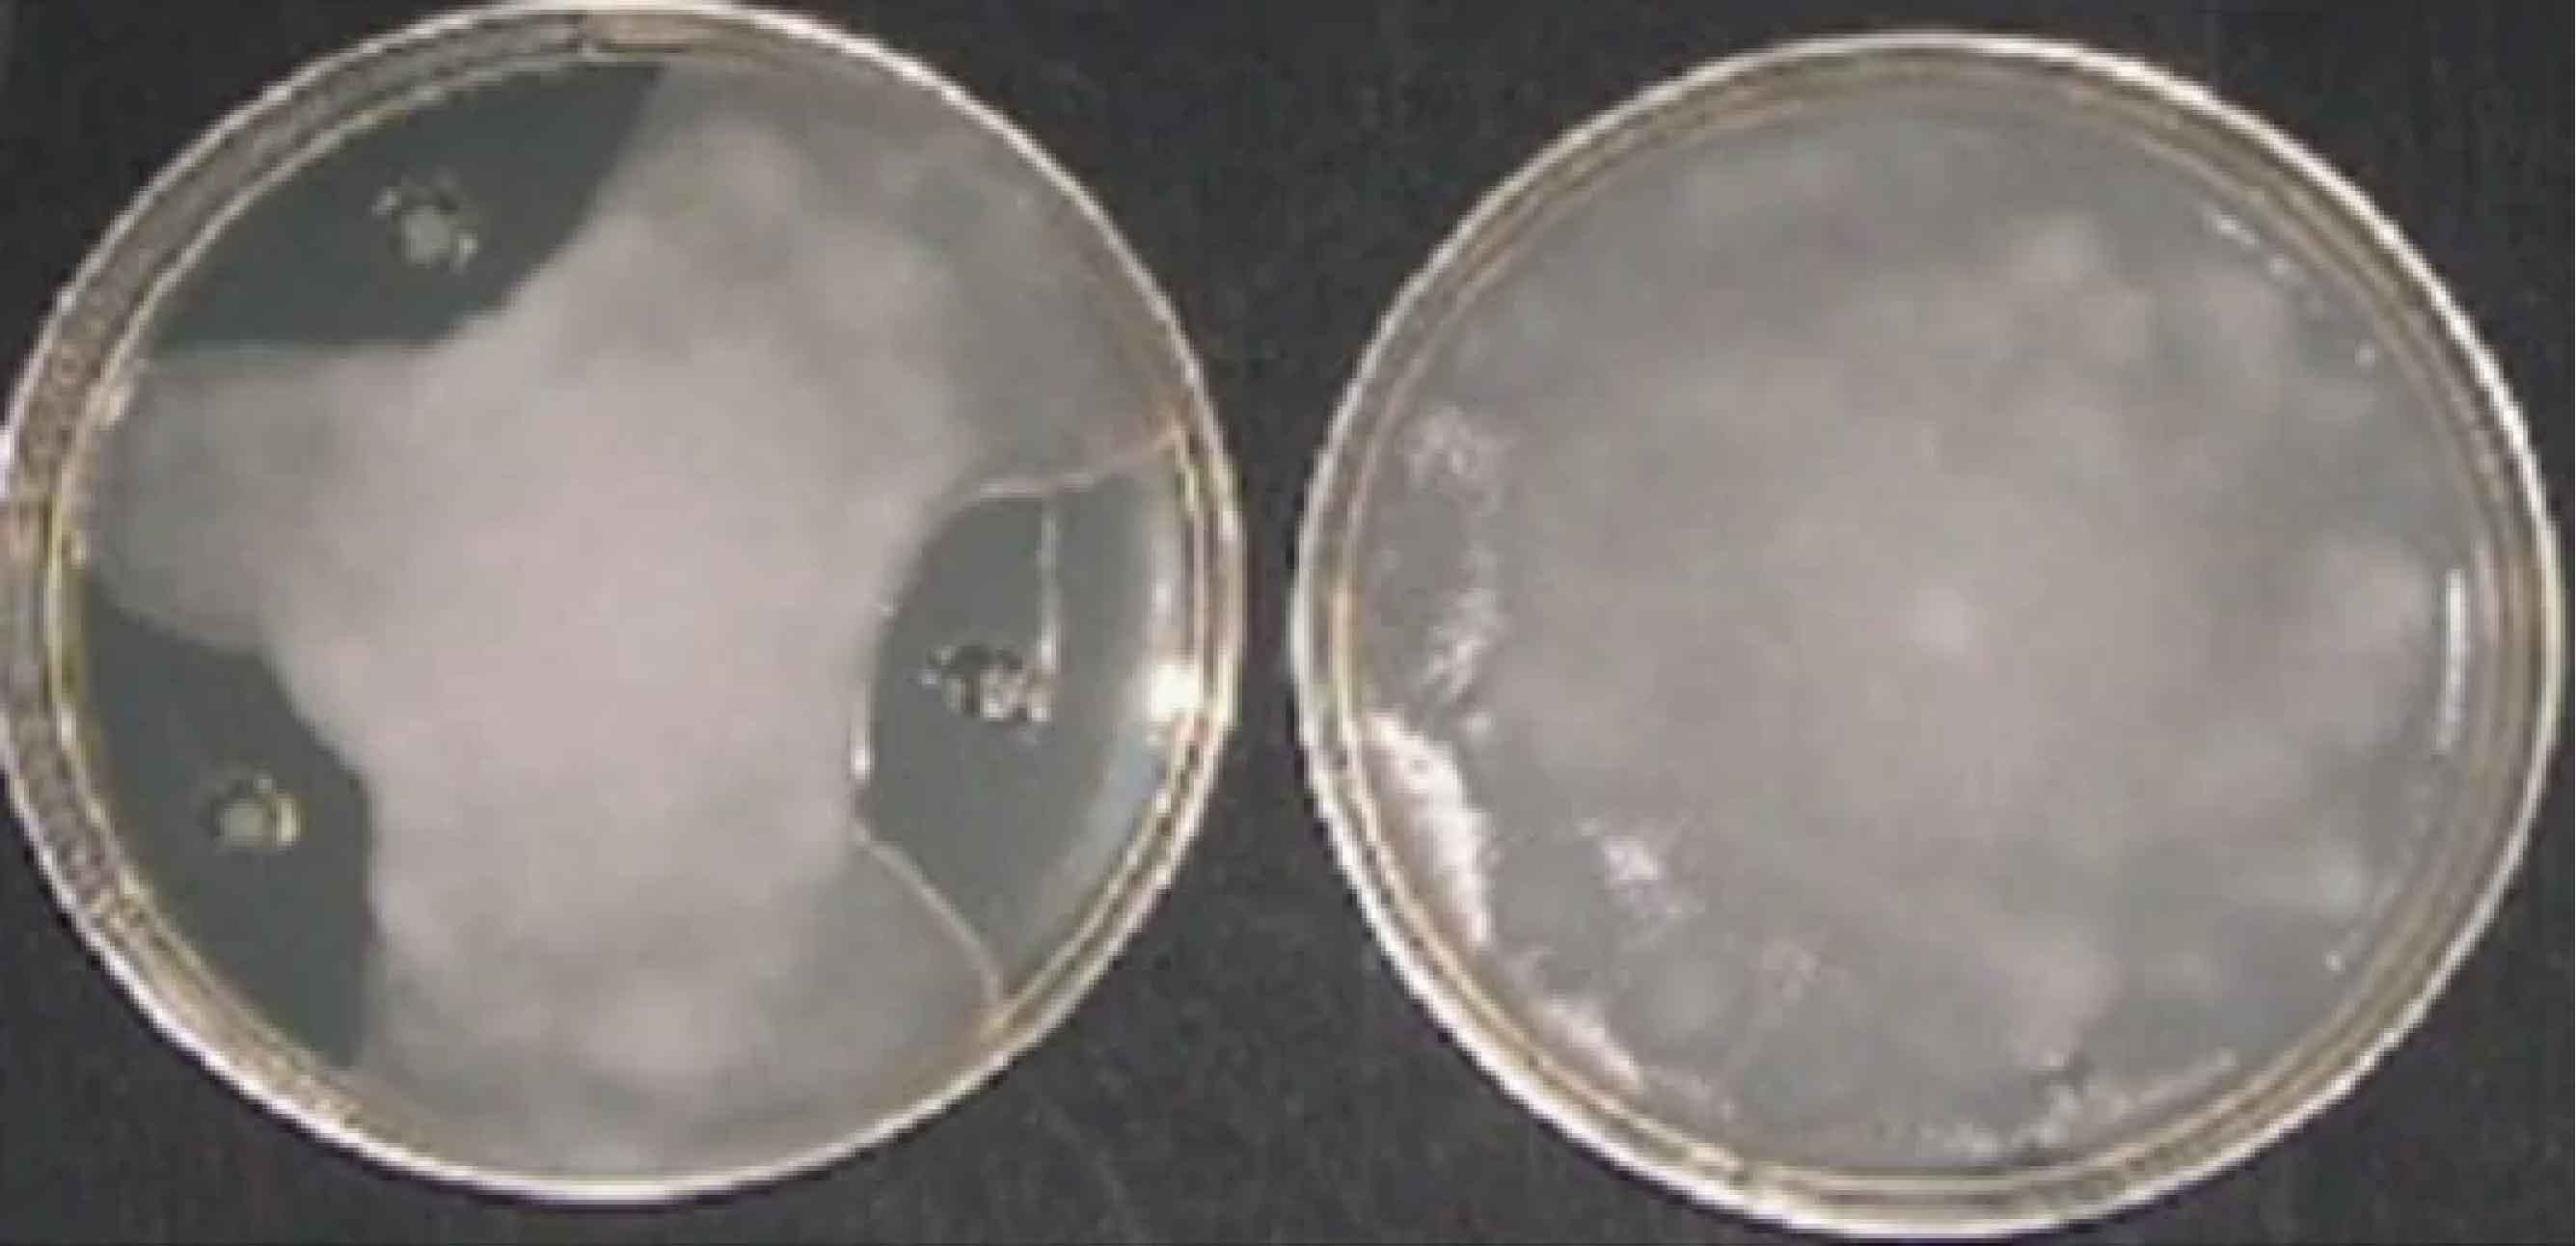
1664507200142428.jpg 3.3-01.jpg

哈茨木霉有效成分由哈茨木霉活菌和活性代謝物載體組成,代謝物包括脂肽類�、氨基酸類活性酶類等物質(zhì)�,使用后農(nóng)作物生長效果是比較好的����,哈茨木霉在農(nóng)業(yè)上使用比較廣泛�,市面上的土壤修復(fù)菌劑中也添加了哈茨木霉�����,可是很多人對于哈茨木霉不了解���,那么哈茨木霉在土壤修復(fù)菌劑中發(fā)揮著怎樣的作用呢?
一�、分類地位及應(yīng)用
哈茨木霉(Trichoderma harzianum)屬于半知菌亞門絲孢綱木霉屬真菌��,是廣泛存在于自然界中的一種微生物����。哈茨木霉是木霉屬中應(yīng)用最為廣泛的生防菌,在生物防治及促進(jìn)作物生長中有廣闊的應(yīng)用前景�����。

圖1哈茨木霉菌落�����、菌絲和孢子形態(tài)
二�����、作用機(jī)制
哈茨木霉能在植物根圍生長并形成保護(hù)層�����,防止根部病原菌的侵染。用來預(yù)防由腐霉菌����、立枯絲核菌��、鐮刀菌�����、黑根霉、柱孢霉���、核盤菌、齊整小核菌等病原菌引起的植物病害�����。
哈茨木霉通過以下幾種機(jī)制來抵御病蟲入侵�����,促進(jìn)作物生長:
1)競爭作用
哈茨木霉菌在植物的根圍、葉圍可以迅速生長���,搶占植物體表面的位點(diǎn),可迅速利用營養(yǎng)和占據(jù)空間���,可在病原真菌的菌落上生長�,致使其消解���。

圖2哈茨木霉對土壤中腐霉菌的競爭作用(每克土壤中含有的腐霉菌菌落數(shù))
2)重寄生作用
纏繞在病原菌的菌絲上生長,產(chǎn)生附著枝或鉤狀分枝吸附于病原菌的菌絲上��,穿透病原菌的菌絲�,使病菌菌絲斷裂�、原生質(zhì)濃縮等�。

圖3哈茨木霉通過重寄生作用將病原菌殺死
3)抗生作用
菌株產(chǎn)生的代謝物質(zhì)可以抑制病原菌的生長定植��,減輕病原菌的危害。
圖4哈茨木霉菌衍生的抗生素的抑菌試驗
4)誘導(dǎo)抗性��、促生作用
木霉菌在植物根系定殖并且產(chǎn)生刺激植物生長和誘導(dǎo)植物防御反應(yīng)的化合物��,改善根系的微環(huán)境,增強(qiáng)植物的長勢和抗病能力�����,提高作物的產(chǎn)量和收益。
5)殺蟲作用
哈茨木霉幾丁質(zhì)酶���,可參與線蟲生防�����。一種絲氨酸蛋白酶��、枯草芽孢桿菌蛋白樣s8蛋白酶、枯草桿菌蛋白酶����、胰凝乳蛋白酶����、Pral及Prb等可直接侵染卵塊����。
真細(xì)微土壤修復(fù)菌劑
哈茨木霉���、貝萊斯芽孢桿菌��、地衣芽孢桿菌��、枯草芽孢桿菌����、膠凍樣類芽孢桿菌
有效活菌數(shù)≥25.0億/g
有機(jī)質(zhì)≥15.0%��,胞外多糖≥1.0mg/g
本產(chǎn)品是選用自主篩選的多種植物益生菌科學(xué)配伍而成的一種土壤修復(fù)菌劑���。
本產(chǎn)品適量用于農(nóng)作物根際土壤,修復(fù)土壤微生態(tài)結(jié)構(gòu)��、補(bǔ)充多種植物益生功能菌群���、恢復(fù)細(xì)菌型土壤和多樣性植物益生菌生態(tài)保護(hù)屏障����,廣譜預(yù)防和減少真菌型土壤和重茬種植中常見的土傳病原真菌(鐮刀菌���、立枯絲核菌��、輪枝菌�����、疫霉�、腐霉等)和根結(jié)線蟲易生長引起的危害。
本產(chǎn)品富含的多樣性功能菌代謝物�,能夠激活作物非特異性免疫機(jī)制����、活化土壤有機(jī)無機(jī)養(yǎng)分、改善土壤團(tuán)粒結(jié)構(gòu)保水蓄肥�、疏松土壤減少板結(jié)沙化�����、沃土肥田壯根護(hù)根���、促進(jìn)養(yǎng)分吸收利用。
用法用量:
噴淋噴霧:稀釋300-500倍均勻噴淋或噴霧��,根據(jù)長勢可間隔重復(fù)使用。
2�����、苗期噴淋:稀釋300-400倍澆出苗水時滴灌或苗床噴淋�,苗期用1-2次����。
3、滴灌沖施:稀釋200-300倍隨水滴灌����,畝用量1-2kg���,可間隔重復(fù)使用�����。
4��、底肥拌肥:按畝用量200-500克拌肥使用����,現(xiàn)拌現(xiàn)用。
5�、設(shè)施燜棚:設(shè)施種植燜棚畝用量1-2kg����。
6����、果樹栽培:可隨冬灌水���、春灌水�、促梢水�����、花前水�、幼果水���、膨果水、秋肥施用��,每次畝用量1-2kg。
鐵皮石斛

黃瓜





苦瓜



枸杞

